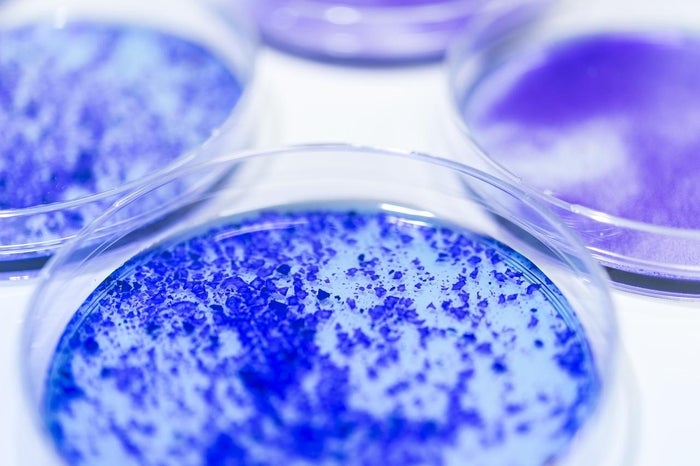
alt

Galderma is the pure-play dermatology category leader. We deliver a synergistic portfolio of flagship brands spanning the full spectrum of the fast-growing self-care dermatology market. Our brands hold leading market positions in their respective product categories and are supported by science-based product differentiation and premium positioning. 2023 was a landmark year for Galderma, marked not only by very strong growth but also by significant progress towards our purpose of advancing dermatology for every skin story.
2023 HIGHLIGHTS: A year of achievements
We unveiled FACE by Galderma™
a cutting-edge aesthetic visualization tool that simulates treatment results in real time
We expanded our geographical footprint
and supported international growth with the new Global Capability Center in Barcelona
We premiered the positive phase III results from the OLYMPIA 2 trial
at the 2023 AAD Annual Meeting where Nemolizumab monotherapy met all primary and key secondary endpoints and demonstrated significant improvements on itch, skin clearance and sleep disturbance in adult patients with prurigo nodularis
We raised approximately USD 1 billion in a private placement
strengthening our balance sheet and further accelerating our organic growth momentum, fueled by our unique Integrated Dermatology Strategy
We unveiled our bold ambition in neuromodulation
at our first Liquid Live event and hosted another successful GAIN Aesthetics event in Dubai where we engaged with the 800 aesthetics practitioners in attendance to learn more about how they can meet their patients individual aesthetic goals
We presented nearly 60 abstracts and posters on data
from across our extensive portfolio at the 2023 World Congress of Dermatology in Singapore. Our significant presence at this event speaks to our unrelenting dedication to delivering innovative solutions that advance dermatology for every skin story
We announced topline results from two phase IIIb trials investigating RelabotulinumtoxinA
Our data demonstrates that RelabotulinumtoxinA significantly improves the appearance of both frown lines and crow’s feet, with rapid-onset action from as early as day one, and long-lasting results
FOREWORD FROM GALDERMA CEO:
Flemming Ørnskov M.D., MPH
OUR COMPETITIVE DIFFERENTIATION:
Galderma’s Integrated Dermatology Strategy
In today’s rapidly changing dermatology market, our Integrated Dermatology Strategy sets Galderma apart. A proven catalyst for growth, it is the driving force behind our strong performance, helping us achieve our goals and our purpose of advancing dermatology for every skin story.
SCALING BLOCKBUSTER PLATFORMS:
Brands highlights
We offer a synergistic portfolio of premium brands with leading market positions in their respective product categories, supported by science-based product differentiation and premium positioning. As the pure-play dermatology category leader, we are building our blockbuster platforms to deliver the broadest portfolio of flagship brands and services in dermatology.
Injectable Aesthetics: Neuromodulators

Dysport® is one of the world’s leading brands of aesthetic neuromodulators with over 100 million treatments delivered in aesthetics indications to date. Alluzience® is the first and only liquid ready-to-use neuromodulator in Europe with rapid onset and effects lasting for up to six months.
Injectable Aesthetics: Fillers & Biostimulators

Restylane® is the original hyaluronic acid filler range with over 65 million treatments worldwide and counting. In 2023, the FDA approved Sculptra® for the correction of fine lines and wrinkles in the cheek area paving the way for Sculptra as a leader in the PLLA-SCA collagen stimulator category.
Dermatological Skincare

Cetaphil® is recognized around the world, with 9 out of 10 U.S. dermatologists recommending it to their patients and in 2023 reached the 1 billion USD net sales mark for the first time. Alastin® is a range of innovative, clinically tested skincare products that help reawaken the skin’s youthful regenerating processes.
Therapeutic Dermatology

Aklief® is the only formula in the world that delivers the newest and most precise retinoid molecule, trifarotene, which rapidly clears acne blemishes and refines acne-prone skin. Included in our portfolio with other dermatological skincare, over-the-counter (OTC), topical and oral prescription brands.
DELIVERING LEADING EDUCATION & SERVICES ACROSS PLATFORMS
Our Galderma Aesthetic Injector Network (GAIN) program supports aesthetics physicians in a variety of ways, including customer education & training, a medical affairs service, and a business service to enable them to grow their business. In 2023, we held over 11,000 training events and reached more than 130,000 aesthetics professionals around the world.
Discover more services and platforms
INNOVATION: At the cutting edge of dermatology
Over the course of our 40-year heritage, we have shown an unwavering commitment to the science of skin. Galderma’s investment in R&D keeps us at the forefront of the latest innovations in dermatology. Our significant investments in science will help us achieve our ambition to become the undisputed category leader in dermatology.
Developing transformative technologies
QM1114
A key component of our neuromodulator pipeline is QM1114, or RelabotulinumtoxinA, a highly-active, complex-free, and ready to-use liquid botulinum toxin A with a proprietary strain and manufactured using a unique state-of-the-art process. In 2023, we announced positive results from two phase IIIb trials investigating RelabotulinumtoxinA for the treatment of glabellar lines (‘frown lines’) and lateral canthal lines (‘crow’s feet’).
Nemolizumab
In 2023, we showcased positive data from four pivotal phase III trials for the treatment of atopic dermatitis and prurigo nodularis with nemolizumab, a first-in-class investigational monoclonal antibody that blocks the signaling of IL-31, a neuroimmune cytokine responsible for driving multiple disease mechanisms.
DELIVERING ON OUR ESG PRIORITIES
Our ambition is to become the leading dermatology company in the world. As a responsible leader in our category, we are committed to making progress toward our environmental, social and governance (ESG) ambition, which is integral to our growth outlook.
Committed to creating a positive impact in key areas
>55% women
in our global workforce
more than 10%
reduction of water intensity in our operations since 2019
Learn more
about how we are advancing our ESG agenda here
>50
manufacturing plant inspections completed over the past 5 years
3 out of 4
factories using 100% renewable electricity
0
factory waste ending up in landfills